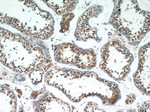
FIBP Antibody in Immunohistochemistry (Paraffin) (IHC (P))

Search
Proteintech
FIBP Polyclonal Antibody
{{$productOrderCtrl.translations['antibody.pdp.commerceCard.promotion.promotions']}}
{{$productOrderCtrl.translations['antibody.pdp.commerceCard.promotion.viewpromo']}}
{{$productOrderCtrl.translations['antibody.pdp.commerceCard.promotion.promocode']}}: {{promo.promoCode}} {{promo.promoTitle}} {{promo.promoDescription}}. {{$productOrderCtrl.translations['antibody.pdp.commerceCard.promotion.learnmore']}}
产品信息
15968-1-AP
种属反应
宿主/亚型
分类
类型
抗原
偶联物
形式
浓度
规格
纯化类型
保存液
内含物
保存条件
运输条件
产品详细信息
Immunogen sequence: MTSELDIFV GNTTLIDEDV YRLWLDGYSV TDAVALRVRS GILEQTGATA AVLQSDTMDH YRTFHMLERL LHAPPKLLHQ LIFQIPPSRQ ALLIERYYAF DEAFVREVLG KKLSKGTKKD LDDISTKTGI TLKSCRRQFD NFKRVFKVVE EMRGSLVDNI QQHFLLSDRL ARDYAAIVFF ANNRFETGKK KLQYLSFGDF AFCAELMIQN WTLGAVDSQM DDMDMDLDKE FLQDLKELKV LVADKDLLDL HKSLVCTALR GKLGVFSEME ANFKNLSRGL VNVAAKLTHN KDVRDLFVDL VEKFVEPCRS DHWPLSDVRF FLNQYSASVH SLDGFRHQAL WDRYMGTLRG CLLRLYHD (1-357 aa encoded by BC014388)
靶标信息
Acidic fibroblast growth factor is mitogenic for a variety of different cell types and acts by stimulating mitogenesis or inducing morphological changes and differentiation. The FIBP protein is an intracellular protein that binds selectively to acidic fibroblast growth factor (aFGF). It is postulated that FIBP may be involved in the mitogenic action of aFGF. Two transcript variants encoding different isoforms have been found for this gene.
仅用于科研。不用于诊断过程。未经明确授权不得转售。
篇参考文献 (0)
生物信息学
蛋白别名: Acidic fibroblast growth factor intracellular-binding protein; aFGF intracellular binding protein; aFGF intracellular-binding protein; FGF-1 intracellular-binding protein; FIBP; unnamed protein product
基因别名: 2010004G08Rik; 2010005N21Rik; 3010027N18Rik; FGFIBP; FIBP; FIBP-1; TROFAS
UniProt ID: (Human) O43427, (Mouse) Q9JI19
Entrez Gene ID: (Human) 9158, (Mouse) 58249